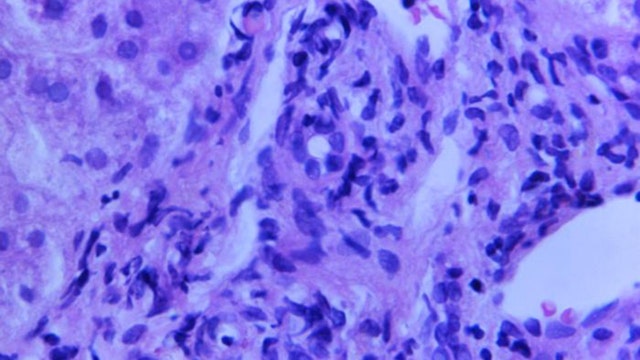
Mystery liver disease in kids: What we know

World's oldest person confirmed as French nun, 118, who loves chocolate and wine
Sister André, born Lucile Randon, has lived through two world wars, the 1918 influenza pandemic, and even survived a COVID-19 infection last year.
Sister André, born Lucile Randon, has lived through two world wars, the 1918 influenza pandemic, and even survived a COVID-19 infection last year.
Mystery liver disease in kids: What we know
A puzzling outbreak of sudden liver disease in nearly 200 children has health authorities in several countries racing to find answers. The illness is being called hepatitis of unknown origin.
A puzzling outbreak of sudden liver disease in nearly 200 children has health authorities in several countries racing to find answers. The illness is being called hepatitis of unknown origin.
Chernobyl: On 36th anniversary of disaster, Russia’s seizure of nuclear plant seen as ‘nightmare’
Tuesday marks the 36th anniversary of the Chernobyl nuclear disaster amid Russia’s invasion of Ukraine. Authorities are working with Ukraine’s officials on ways to protect Chernobyl’s most critical areas.
Tuesday marks the 36th anniversary of the Chernobyl nuclear disaster amid Russia’s invasion of Ukraine. Authorities are working with Ukraine’s officials on ways to protect Chernobyl’s most critical areas.
Nearly 200 cases of mystery liver disease in children
European health officials say they have not found a link between cases of a mysterious liver disease outbreak in children. Around 190 cases have been reported worldwide, of which 140 are in Europe.
European health officials say they have not found a link between cases of a mysterious liver disease outbreak in children. Around 190 cases have been reported worldwide, of which 140 are in Europe.
Girl left behind on rail platform reunited with mom thanks to good Samaritan, officers
A little girl became stranded at a Melbourne train station when she jumped onto the platform and the train doors closed before her mother could follow. Thankfully, some kind strangers were there to help.
A little girl became stranded at a Melbourne train station when she jumped onto the platform and the train doors closed before her mother could follow. Thankfully, some kind strangers were there to help.
Beijing enforces lockdowns, expands COVID-19 mass testing amid outbreak
Residents lined up for throat swabs across Beijing as mass testing was expanded to 11 city districts. Beijing has a total of 92 virus cases since an outbreak was discovered five days ago.
Residents lined up for throat swabs across Beijing as mass testing was expanded to 11 city districts. Beijing has a total of 92 virus cases since an outbreak was discovered five days ago.
Kane Tanaka, world's oldest person, dies at 119 in Japan
Kane Tanaka was born on Jan. 2, 1903, the same year the Wright brothers took flight for the first time.
Kane Tanaka was born on Jan. 2, 1903, the same year the Wright brothers took flight for the first time.
3 Sumatran tigers killed by animal traps as worldwide numbers dwindle to 400
Three critically endangered Sumatran tigers are dead after being caught in traps in Indonesia. Only about 400 are left in the wild, experts say.
Three critically endangered Sumatran tigers are dead after being caught in traps in Indonesia. Only about 400 are left in the wild, experts say.
French President Emmanuel Macron wins 2nd term
The second five-year term for the 44-year-old centrist spared France and Europe from the seismic upheaval of having firebrand populist Marine Le Pen at the helm.
The second five-year term for the 44-year-old centrist spared France and Europe from the seismic upheaval of having firebrand populist Marine Le Pen at the helm.
Zelenskyy meets top-level US delegation Blinken and Austin, Ukraine official says
The U.S. secretaries of state and defense arrived in Kyiv Sunday for the highest-level visit to Kyiv by an American delegation since the start of Russia’s invasion.
The U.S. secretaries of state and defense arrived in Kyiv Sunday for the highest-level visit to Kyiv by an American delegation since the start of Russia’s invasion.
Shipping, manufacturing delays upset board game industry
Board game publishers say supply chain and manufacturing issues have forced them to raise prices.
Board game publishers say supply chain and manufacturing issues have forced them to raise prices.
Ed Sheeran releases music video filmed in Ukraine days before Russian invasion
The singer-songwriter will also donate proceeds to the country.
The singer-songwriter will also donate proceeds to the country.
Japanese tour boat missing in frigid waters with 26 on board; 10 found dead
The search for the others is still ongoing after the boat sent a distress call on Saturday afternoon saying it was sinking.
The search for the others is still ongoing after the boat sent a distress call on Saturday afternoon saying it was sinking.
Brisk walking may slow biological aging, study suggests
Scientists in England said they have found a link between brisk walking and fewer biological markers that may indicate older age in people.
Scientists in England said they have found a link between brisk walking and fewer biological markers that may indicate older age in people.
Blinken, Austin to visit Ukraine Sunday, Zelenskyy says
Secretary of State Blinken, Secretary of Defense Austin would be the highest-ranking U.S. officials to visit Ukraine since the war began.
Secretary of State Blinken, Secretary of Defense Austin would be the highest-ranking U.S. officials to visit Ukraine since the war began.
Phoenix Ghost: Pentagon fast-tracks mystery drone for Ukraine. What is it?
The Pentagon has fast-tracked a new tactical drone to send to Ukraine amid its fight against Russian aggression. But what is it?
The Pentagon has fast-tracked a new tactical drone to send to Ukraine amid its fight against Russian aggression. But what is it?
Ukraine: Russians trying to storm steel mill where hundreds of civilians are sheltering
Efforts to evacuate Ukrainian civilians to safer areas continued Saturday amid air strikes on a steel mill where 1,000 civilians are sheltering underground.
Efforts to evacuate Ukrainian civilians to safer areas continued Saturday amid air strikes on a steel mill where 1,000 civilians are sheltering underground.
Florence + The Machine dedicates new music video filmed in Kyiv to Ukrainians
“Dedicated to the spirit, creativity and perseverance of our brave Ukrainian friends,” a message read at the end of the music video.
“Dedicated to the spirit, creativity and perseverance of our brave Ukrainian friends,” a message read at the end of the music video.
Ukraine military blows up bridge ahead of advancing Russian army, video shows
The 13-second clip, which is shot in a first-person view, shows soldiers hiding behind a vehicle before an explosion on the road in front of them sends smoke rising into the air.
The 13-second clip, which is shot in a first-person view, shows soldiers hiding behind a vehicle before an explosion on the road in front of them sends smoke rising into the air.
Ukraine: Russia shifts elite troops from Mariupol to new battleground
Ukrainian authorities say Russia has shifted a dozen crack units from the shattered port of Mariupol to eastern Ukraine and is pounding away at cities across the region.
Ukrainian authorities say Russia has shifted a dozen crack units from the shattered port of Mariupol to eastern Ukraine and is pounding away at cities across the region.